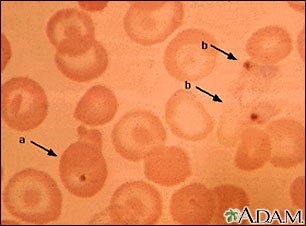
Malaria, photomicrograph of cellular parasites

Overview
Malaria is a disease caused by parasites. This picture shows dark orange-stained malaria parasites inside red blood cells (a) and outside the cells (b). Note the large cells that look like targets; it is unknown how these target cells are related to this disease.
Review Date 3/11/2024
Updated by: Frank D. Brodkey, MD, FCCM, Associate Professor, Section of Pulmonary and Critical Care Medicine, University of Wisconsin School of Medicine and Public Health, Madison, WI. Also reviewed by David C. Dugdale, MD, Medical Director, Brenda Conaway, Editorial Director, and the A.D.A.M. Editorial team.